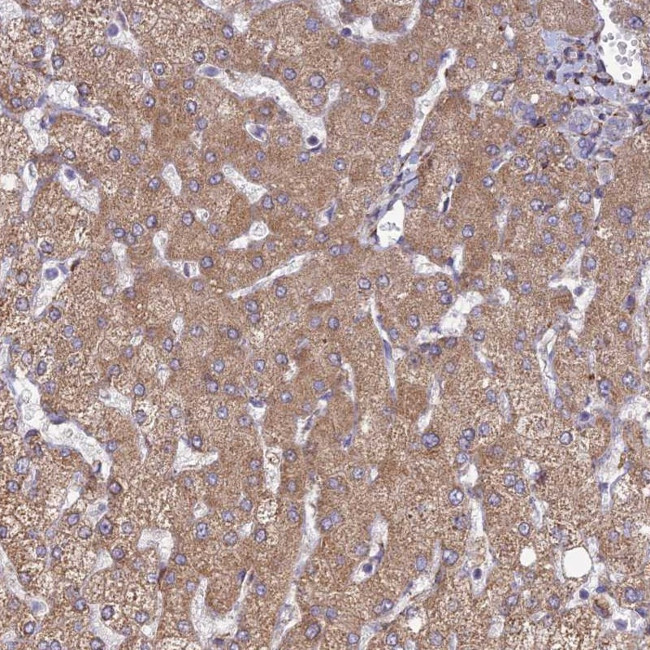
RCN3 Antibody in Immunohistochemistry (Paraffin) (IHC (P))

Search
Invitrogen
RCN3 Polyclonal Antibody
{{$productOrderCtrl.translations['antibody.pdp.commerceCard.promotion.promotions']}}
{{$productOrderCtrl.translations['antibody.pdp.commerceCard.promotion.viewpromo']}}
{{$productOrderCtrl.translations['antibody.pdp.commerceCard.promotion.promocode']}}: {{promo.promoCode}} {{promo.promoTitle}} {{promo.promoDescription}}. {{$productOrderCtrl.translations['antibody.pdp.commerceCard.promotion.learnmore']}}
产品信息
PA5-60252
种属反应
宿主/亚型
分类
类型
抗原
偶联物
形式
浓度
规格
纯化类型
保存液
内含物
保存条件
运输条件
RRID
产品详细信息
Immunogen sequence: DGWVSLAELR AWIAHTQQRH IRDSVSAAWD TYDTDRDGRV GWEELRNATY GHYAPGEEFH DVEDAETYK
Highest antigen sequence identity to the following orthologs: Mouse - 97%, Rat - 97%.
靶标信息
Probable molecular chaperone assisting protein biosynthesis and transport in the endoplasmic reticulum (PubMed:16433634, PubMed:28939891). Required for the proper biosynthesis and transport of pulmonary surfactant-associated protein A/SP-A, pulmonary surfactant-associated protein D/SP-D and the lipid transporter ABCA3. By regulating both the proper expression and the degradation through the endoplasmic reticulum-associated protein degradation pathway of these proteins plays a crucial role in pulmonary surfactant homeostasis. Has an anti-fibrotic activity by negatively regulating the secretion of type I and type III collagens (PubMed:28939891). This calcium-binding protein also transiently associates with immature PCSK6 and regulates its secretion (PubMed:16433634). [UniProt]
仅用于科研。不用于诊断过程。未经明确授权不得转售。
篇参考文献 (0)
生物信息学
蛋白别名: EF-hand calcium-binding protein RLP49; HRP-iso; reticulocabin; reticulocalbin 3, EF-hand calcium binding domain; Reticulocalbin-3
基因别名: RCN3; RLP49; UNQ239/PRO272
UniProt ID: (Human) Q96D15
Entrez Gene ID: (Human) 57333